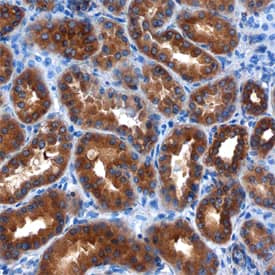
LRIG1 antibody in Human Kidney by Immunohistochemistry (IHC-P).

Human LRIG1 Antibody
R&D Systems, part of Bio-Techne | Catalog # MAB7498


Key Product Details
Species Reactivity
Validated:
Cited:
Applications
Validated:
Cited:
Label
Antibody Source
Product Specifications
Immunogen
Ala35-Ser779
Accession # Q96JA1
Specificity
Clonality
Host
Isotype
Scientific Data Images for Human LRIG1 Antibody
Detection of LRIG1 in LNCaP Human Cell Line by Flow Cytometry.
LNCaP human prostate cancer cell line was stained with Mouse Anti-Human LRIG1 Monoclonal Antibody (Catalog # MAB7498, filled histogram) or isotype control antibody (Catalog # MAB0041, open histogram), followed by Allophycocyanin-conjugated Anti-Mouse IgG Secondary Antibody (Catalog # F0101B).LRIG1 in SK‑BR‑3 Human Cell Line.
LRIG1 was detected in immersion fixed SK-BR-3 human breast cancer cell line using Mouse Anti-Human LRIG1 Monoclonal Antibody (Catalog # MAB7498) at 10 µg/mL for 3 hours at room temperature. Cells were stained using the Northern-Lights™ 557-conjugated Anti-Mouse IgG Secondary Antibody (red; Catalog # NL007) and counter-stained with DAPI (blue). Specific staining was localized to cytoplasm and cell surfaces. View our protocol for Fluorescent ICC Staining of Cells on Coverslips.LRIG1 in Human Kidney.
LRIG1 was detected in immersion fixed paraffin-embedded sections of human kidney using Mouse Anti-Human LRIG1 Monoclonal Antibody (Catalog # MAB7498) at 15 µg/mL overnight at 4 °C. Before incubation with the primary antibody, tissue was subjected to heat-induced epitope retrieval using Antigen Retrieval Reagent-Basic (Catalog # CTS013). Tissue was stained using the Anti-Mouse HRP-DAB Cell & Tissue Staining Kit (brown; Catalog # CTS002) and counter-stained with hematoxylin (blue). Specific staining was localized to cytoplasm of epithelial cells in convoluted tubules. View our protocol for Chromogenic IHC Staining of Paraffin-embedded Tissue Sections.Applications for Human LRIG1 Antibody
CyTOF-ready
Flow Cytometry
Sample: LNCaP Human Cell Line
Immunocytochemistry
Sample: Immersion fixed SK‑BR‑3 human breast cancer cell line
Immunohistochemistry
Sample: Immersion fixed paraffin-embedded sections of human kidney
Reviewed Applications
Read 3 reviews rated 3.7 using MAB7498 in the following applications:
Formulation, Preparation, and Storage
Purification
Reconstitution
Formulation
Shipping
Stability & Storage
- 12 months from date of receipt, -20 to -70 °C as supplied.
- 1 month, 2 to 8 °C under sterile conditions after reconstitution.
- 6 months, -20 to -70 °C under sterile conditions after reconstitution.
Background: LRIG1
LRIG1 (leucine-rich repeats and Ig-like domains-1; also LIG-1) is an approximately 134-145 kDa glycoprotein that belongs to the LRIG gene family. It is widely expressed and appears on the surface of prostatic epithelium, endothelial cells, vascular and visceral smooth muscle, mammary epithelium, cardiac muscle, keratinocytes and neurons. LRIG1 is believed to negatively regulate the ErbB family of receptors. In particular, and in a ligand-independent manner, LRIG1 complexes with all four ErbBs, promoting their ubiquitination and decreasing their number. Alternatively, LRIG1 is suggested to bind to the ErbBs, preventing their dimerization and signal transduction. Mature human LRIG1 is a 1059 amino acid (aa) type I transmembrane protein. It contains a large 760 amino acid (aa) extracellular domain (ECD) (aa 35-794) plus a 278 aa cytoplasmic region. The ECD contains 17 LRRs (aa 35‑491) and three C2-type Ig-like domains (aa 495-780). These two domain types are each sufficient for EGFR binding. There are two potential alternative splice forms. One contains a 27 aa insertion after Gly874, while another shows a 24 aa insertion after Lys387 coupled to a Gln substitution for aa 644-691. The LRIG1 ECD undergoes proteolysis, generating 100-110 and 55-60 kDa soluble fragments. Over aa 35‑779, human LRIG1 shares 90% aa sequence identity with mouse LRIG1.
Long Name
Alternate Names
Gene Symbol
UniProt
Additional LRIG1 Products
Product Documents for Human LRIG1 Antibody
Product Specific Notices for Human LRIG1 Antibody
For research use only